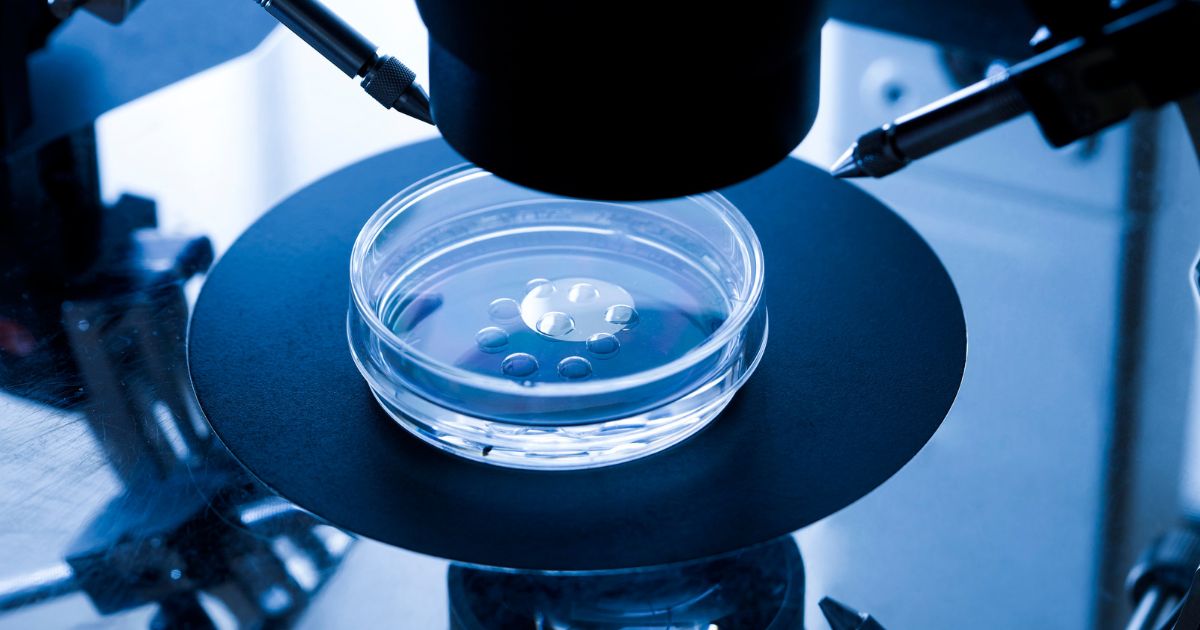

Fertility Assessment Services at Khan’s Medical Clinic
Welcome to Khan’s Medical Clinic, a trusted healthcare provider in Manchester committed to supporting individuals and couples on their path to parenthood.
Why Choose Our Infertility Assessment Clinic
We know how stressful it can be when you’re waiting months for a fertility assessment, or when strict NHS criteria mean you may not even get an appointment. That’s why we created our Fertility Assessment Clinic—to give couples quicker, more accessible support on their journey to parenthood.
Led by an experienced consultant, we take time to listen to both partners, carry out the right investigations, and look for common causes such as PCOS. For many couples, small but meaningful lifestyle and diet changes can make a big difference.
Our service is not full infertility treatment, but a cost-effective first step—helping you understand your options, take action sooner, and move closer to your dream of becoming parents.
Our Approach to Fertility Care
We understand how difficult and frustrating the journey to parenthood can feel—especially when faced with long NHS waiting lists or strict criteria that may prevent you from being seen. In many hospitals, waiting times for a fertility assessment can stretch into several months, and women with a BMI above 30–35 may not even be offered an initial evaluation.
At our Fertility Assessment Clinic, we aim to bridge this gap by offering couples timely, compassionate, and affordable support. Our consultant-led service focuses on understanding your unique situation with:
- A detailed history from both partners
- Careful evaluation to identify possible causes of infertility
- Special attention to female factor infertility,
particularly PCOS - Investigations and review of results in a clear, supportive manner
We believe that for many couples, fertility can often be improved through lifestyle and dietary changes, provided there are no significant underlying medical concerns. Our role is to guide you through these steps, helping you move forward with confidence and hope.
While we do not provide full infertility treatments, our mission is to offer a thorough, cost-effective fertility assessment—giving couples who may not qualify, or who are waiting months for an NHS appointment, the chance to take important steps toward achieving their dream of becoming parents.
Fertility Treatment Services
Comprehensive Fertility Treatment Services
Our clinic offers a comprehensive range of fertility treatment services, designed to address a wide array of reproductive concerns.

Our Approach
Our fertility specialists employ the latest advancements in reproductive medicine to develop customized treatment plans, maximizing the chances of successful conception. Our services include fertility assessments, ovulation induction, intrauterine insemination (IUI), in vitro fertilization (IVF), intracytoplasmic sperm injection (ICSI), genetic screening, and fertility preservation options such as egg freezing.

Expert Fertility Specialists
At Khan’s Medical Clinic, our fertility specialists are highly skilled and experienced in the field of reproductive medicine. They utilize their expertise to conduct thorough assessments, diagnose underlying causes, and recommend the most appropriate fertility treatments tailored to your individual needs. Our team is committed to providing compassionate care, open communication, and continuous support throughout your fertility journey.
State-of-the-Art Facilities
Our clinic is equipped with state-of-the-art facilities and cutting-edge technology, ensuring that you receive the highest standard of care. We have advanced laboratories for sperm analysis, embryo culture, and genetic testing, as well as comfortable consultation rooms and recovery areas. Our commitment to maintaining a modern and welcoming environment ensures your comfort and peace of mind during your fertility treatment.
